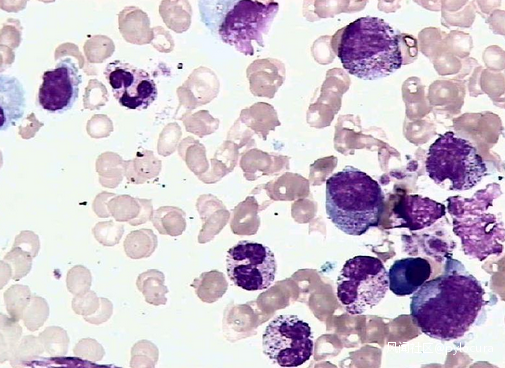

幽門螺桿菌導致的胃外疾病,你知道嗎?_風聞
pylocura-2021-01-18 16:46
幽門螺旋桿菌(HP)是一種螺旋形、微需氧、對生長條件要求十分苛刻的革蘭氏陰性桿菌。1983年首次從慢性活動性胃炎患者的胃粘膜活檢組織中分離成功,是目前所知能夠在人胃中生存的惟一微生物種類。幽門螺旋桿菌感染可引起慢性胃炎,消化性潰瘍,胃癌,胃黏膜相關淋巴組織惡性淋巴瘤等胃內疾病。但幽門螺桿菌導致的胃外疾病,你知道嗎?

第一,幽門螺桿菌與缺鐵性貧血。HP導致缺鐵性貧血的可能機制為HP感染直接導致胃黏膜損傷和失血,進而導致慢性萎縮性胃炎,壁細胞泌酸功能減弱,可降低胃液酸度和維生素C濃度,胃酸和維生素C濃度降低,可影響高鐵還原成亞鐵,腸道對亞鐵的吸收從而減少,另外高鐵可通過Fenton反應(芬頓反應)產生自由基,損傷胃腸黏膜上皮細胞,減少腸道鐵的吸收,最終導致缺鐵性貧血。

第二,幽門螺桿菌與特發性血小板減少性紫癜。HP感染可引起慢性免疫刺激,與血小板某些抗原具有相同或相似的抗原表位,從而誘導機體產生血小板自身抗體,破壞血小板。國外有報道18例特發性血小板減少性紫癜病人中,11例胃HP感染,HP根治後,8例病人血小板計數均有顯著升高,其中6例患者血小板自身抗體消失。
第三,幽門螺桿菌與巨幼細胞性貧血。HP感染可誘導機體特異性體液和細胞免疫,從而損傷胃黏膜細胞,引起慢性萎縮性胃炎,導致壁細胞受損,胃酸、胃蛋白酶和內因子分泌降低,因此食物中VitB12釋放障礙及其與內因子結合減少,影響VitB12吸收。

第四,幽門螺桿菌與過敏性紫癜。HP感染可誘發速髮型超敏反應,釋放抗原,刺激漿細胞產生特異性HP-IgE,進而導致肥大細胞被激活,釋放出組胺,激肽原酶,硫痠軟骨素等,從而引起血管擴張、通透性增加,出現血漿滲出和水腫。

第五,幽門螺桿菌與肝癌。①研究發現,HBV-DNA陽性,HBeAg陽性者HP感染率高達75.6%,提示HP感染可能對乙肝病毒的複製有促進作用。而通過對原發性肝癌的測序,發現肝癌組織螺桿菌屬16SrRNA序列與HP的16SrRNA序列有97.8%的同源性,通過14碳呼氣試驗對肝癌病人進行檢測,發現HP感染高達85.5%,提示HP與肝癌有相關性。②過去長期認為HP僅寄生於胃黏膜,但近來,研究人員在膽汁及肝臟中同樣檢測到HP的存在。HP可能通過oddi括約肌逆流至膽道進入肝臟,也可能通過門靜脈循環或淋巴循環到達肝臟。③HP感染過程中可釋放多種細胞因子,自由基以及一氧化氮等,這些與肝癌的侵襲轉移密切相關,在肝癌發展過程中,HP可能起到橋樑或協同作用,具體機制還需要進一步研究。

第六,幽門螺桿菌與冠心病。HP可以通過以下機制引起冠心病:①炎症反應,HP感染可引起炎症細胞增多,聚集和激活,這些炎症細胞可分泌TNF-α,IL-1,IL-6等細胞因子,增加冠狀動脈平滑肌損傷過程的應答。②影響脂質代謝,TNF-α可抑制脂蛋白酶的活性,引起脂代謝紊亂,血漿膽固醇升高,高密度脂蛋白降低,氧自由基濃度升高,促進冠狀動脈粥樣斑塊形成。③維生素B12和葉酸吸收不良,導致同型半胱氨酸水平升高,高半胱氨酸可以抑制內皮細胞分泌NO,促進血小板聚集和血管收縮,進而導致血栓的形成。

第七,幽門螺桿菌與皮膚病。據相關文獻,1998年加斯巴里尼醫生就發現,55%慢性頑固性蕁麻疹患者的胃內可查出幽門螺桿菌,經抗菌治療消除幽門螺桿菌後,有81%患者蕁麻疹不再發生。而且,這類病人體內往往存在特異性IgE型抗幽門螺桿菌抗體,可持續釋放抗原,導致人體的肥大細胞和嗜鹼性粒細胞脱顆粒引起組胺釋放。體內外研究也發現,HP可引起人體局部的微血管損傷和功能失調, 這可誘發或加重皮膚水腫或風團的形成。此外,有研究發現,幽門螺桿菌通過改變胃黏膜的通透性,促進組胺的釋放,引起人體內的免疫功能紊亂,誘發機體體液免疫失去平衡,產生特異性抗幽門螺桿菌IgE。也有人報道,區域性斑禿病人與健康成人相比,HP感染率明顯升高,還有報道説銀屑病,酒糟鼻也可能與HP感染有一定相關性,久治不愈的皮膚病,予以HP根治後,症狀有可能得到改善。

第八,幽門螺桿菌與2型糖尿病。①HP感染導致的慢性炎症反應可促進血小板活化及血小板、白細胞聚集,在胰島素抵抗中發揮一定的作用;②HP感染可導致組織及全身的氧化應激,增加循環中過氧化脂濃度,進而導致胰島素抵抗、胰島β細胞功能障礙、糖耐量降低、糖尿病的形成;③HP感染可導致胃腸內激素水平紊亂。使生長抑素水平下降,胃泌素的釋放增加。生長抑素調節胰島素的分泌,對胰島素的釋放有抑制作用,胃泌素能減少小腸對糖的吸收,並刺激糖依賴性胰島素的分泌,兩種激素平衡被打亂後通過負反饋導致胰島素釋放的增加,產生胰島素抵抗,進而促進糖尿病的發生。

第九,幽門螺桿菌與口腔疾病。有研究者通過32例慢性牙周炎患者口腔不同部位幽門螺桿菌檢測發現,口腔牙菌斑、唾液、舌背黏膜、頰黏膜和黏膜等部位存在着幽門螺桿菌,且以牙菌斑中居多。研究發現,HP感染可能與牙周炎、口腔黏膜扁平苔蘚、複發性口腔潰瘍、齲病、口腔癌和口臭相關,根治HP後,病程縮短、復發週期延長、自覺症狀減輕。(作者:張雨雨,來源:醫學界消化頻道)